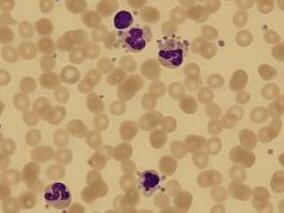
免疫性血小板减少症妊娠女性可能不需要接受治疗

-
免疫性血小板减少症妊娠女性可能不需要接受治疗
环球医学资讯
2016年10月27日
点击量:299
1小时条评论妊娠期免疫性血小板减少症(ITP)的治疗选择有限。2016年9月,发表在《Blood》上的一项研究对静脉注射免疫球蛋白(IVIg)和糖皮质激素治疗ITP的有效性进行了比较。结果显示,IVIg和糖皮质激素疗效欠佳。 妊娠期...
-
即使没患贫血 铁剂也能改善性青春期月经性疲劳
环球医学资讯
2016年10月27日
点击量:347
1小时条评论女性月经来潮,即使不存在贫血也均存在铁缺乏相关疲劳增加的风险。2016年10月,发表在《Am J Hematol》的一项研究显示,在不贫血患者中,铁剂不会明显影响血红蛋白浓度,但会明显改善疲劳。 女性月经来潮,伴有...
-
产前左乙拉西坦和托吡酯暴露降低学龄儿童的认知功能?
环球医学资讯
2016年10月18日
点击量:463
1小时条评论既往研究表明,产前抗癫痫药物暴露可能会增加儿童自闭症的风险。2016年8月,发表在《Neurology》的一项在英国开展的横断面观察性研究,考察了暴露于左乙拉西坦、托吡酯或丙戊酸钠的学龄儿童的认知功能。 目的:...
-
一例产后重症感染患者的药学监护
环球医学资讯
2016年10月14日
点击量:599
1小时条评论【病历导读】 患者,女性,32岁,以 弥漫性血管内凝血、失血性休克、软产道裂伤、低蛋白血症、急性肾功能衰竭入院;患者入院后行开腹探查+子宫次全切除+双侧髂内动脉阻断+阴道裂伤修补术(术中出血8000ml);累...
-
多学科讨论:美丽有代价 化妆品让绝经年龄提前?
环球医学资讯
2016年10月14日
点击量:412
1小时条评论女性易受使用化妆品美化自己的社会压力的影响。2016年9月,发表在《Fertil Steril》的一项由美国科学家进行的评价,考察了化妆品使用和绝经年龄是否存在关联。请看本期多学科讨论组临床药师各抒己见为您梳理本文...
-
初级医疗心理干预对产后抑郁症的疗效
环球医学资讯
2016年10月14日
点击量:372
1小时条评论产后抑郁症被称为隐形杀手,甚至会危及母亲和孩子的生命安全。2016年9月,发表在《Ann Fam Med》的一项由英国科学家进行的荟萃分析,考察了初级医疗心理干预对产后抑郁症的疗效。 目的:产后抑郁症影响着10%~15...
-
妊娠期鸦片类药物脱毒对胎儿是否有害?
环球医学资讯
2016年10月12日
点击量:379
1小时条评论目前有关妊娠患者阿片依赖管理没有推荐在妊娠期内开展脱毒,因为存在早产、胎儿宫内窒息或胎儿死亡的潜在风险。2016年9月,发表在《Am J Obstet Gynecol》的一项回顾性分析旨在大量患者中,评估妊娠期内4种不同方...
-
母体静脉药物滥用史增加妊娠期同种免疫风险
环球医学资讯
2016年10月12日
点击量:283
1小时条评论轶事证据表明静脉药物滥用与同种免疫相关;但是,已发表的数据仅限于病例报告。2016年9月,发表在《Am J Obstet Gynecol》的一项回顾性队列研究考察了是否静脉药物滥用女性同种免疫风险会增加。结果表明,母体静...
-
石油和天然气活性成分对人类生殖系统有不良影响
环球医学资讯
2016年10月08日
点击量:331
1小时条评论2016年9月,发表在《Fertil Steril.》的一项系统评价评估了石油和天然气提取过程与人类生殖之间的相关性。结果表明,暴露于石油和天然气活性成分对人类生殖具有消极影响。 系统评价识别出45篇石油和天然气活...
-
剖腹产后初始使用阿片类女性:哪些人更容易持续使用?
环球医学资讯
2016年10月08日
点击量:244
1小时条评论过去十年中,女性中阿片类相关死亡的发生率增加了5倍。对于许多女性,她们的初始阿片类暴露将发生在常规的医学护理机构中。美国大约三分之一的分娩是剖腹产,阿片类是常用的术后疼痛管理。2016年9月,发表在《Am ...

会员登录


网友评论
Yvette05-22
脱发一直是很多人的困扰,希望能广泛应用。
Ada305-22
补碘知识非常全面,获益匪浅。
penelope05-22
“盐重”问题确实需要重视